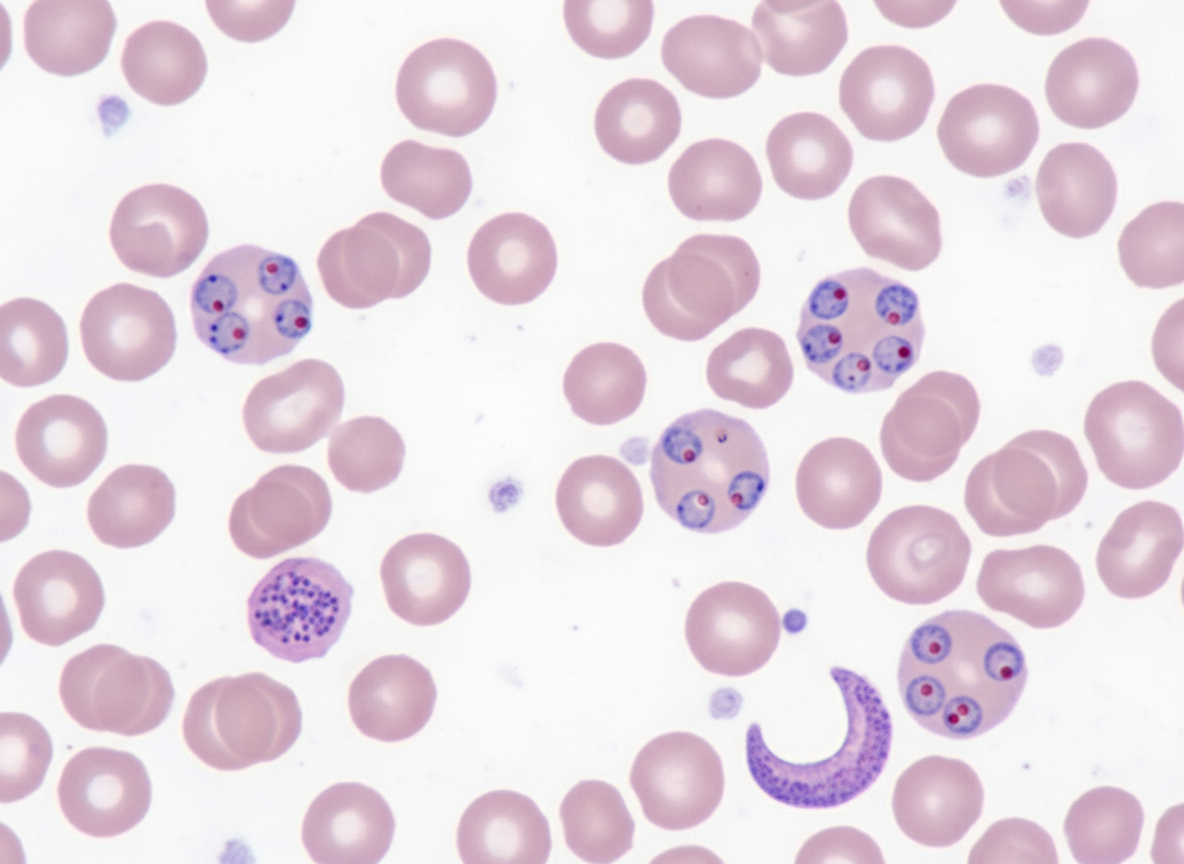
Image for question 382

Formaldehyde gas sterilization is employed for which of the following?
A patient from a tribal area of Jharkhand presents with fever for the last 3 days. Peripheral blood is collected and stained with Giemsa. A diagnosis of malaria is made. The smear is shown in the figure. What is the likely causative species?
Which animal is primarily used for the production of monoclonal antibodies?
A bacterium divides every 20 minutes. If the population starts with a single bacterium and grows exponentially for 3 hours, how many bacteria will be present?
Pasteur developed vaccines for which of the following diseases?
Which method is used for sterilization by steam under pressure?
What is the approximate ratio of anaerobes to aerobes found in normal human stool?
NNN media is used for the culture of which organism?
Louis Pasteur is associated with all of the following except:
Which immunoglobulin acts as the B cell receptor?
Explanation: **Explanation:** **Formaldehyde gas** is a high-level disinfectant and sterilant that acts by **alkylation** of amino, carboxyl, and hydroxyl groups in microbial proteins and nucleic acids. 1. **Why Option D is Correct:** Formaldehyde gas (generated by adding potassium permanganate to formalin or by heating paraformaldehyde) is the traditional agent of choice for the **fumigation of operation theaters (OTs)**, wards, and laboratories. It is highly effective against bacteria, spores, and viruses. After the procedure, the gas must be neutralized using ammonia spray because formaldehyde is pungent, irritating to the mucous membranes, and potentially carcinogenic. 2. **Why Other Options are Incorrect:** * **Option A (Heart-lung machines):** These are complex, heat-sensitive instruments typically sterilized using **Ethylene Oxide (EtO)** gas or cold sterilization with glutaraldehyde/peracetic acid. * **Option B (Glass materials):** Glassware is best sterilized using **Dry Heat (Hot Air Oven)** at 160°C for 2 hours, which is more efficient and leaves no toxic residue. * **Option C (Paper and cloth):** These are porous materials best sterilized by **Moist Heat (Autoclaving)** at 121°C for 15 minutes, as steam penetrates fabrics more effectively than formaldehyde gas. **High-Yield Clinical Pearls for NEET-PG:** * **Mechanism:** Alkylation of proteins and DNA. * **Neutralization:** Ammonia is used to remove residual formaldehyde fumes. * **Modern Alternative:** Many hospitals are replacing formaldehyde with **Hydrogen Peroxide Vapor (HPV)** for OT fumigation because HPV is non-carcinogenic and breaks down into harmless water and oxygen. * **Low-Temperature Steam Formaldehyde (LTSF):** Used for heat-sensitive medical devices at 60-80°C.
Explanation: ***Plasmodium falciparum*** - **Multiple ring forms** per RBC and **double chromatin dots** are characteristic features seen on Giemsa-stained smears, along with **appliqué position** (rings attached to RBC membrane). - **No RBC enlargement** is observed, and **crescent-shaped gametocytes** are pathognomonic when present; high prevalence in **tribal areas of Jharkhand**. *Plasmodium vivax* - Shows **enlarged RBCs** with **Schüffner's dots** and typically **single ring forms** per infected cell. - **Oval-shaped gametocytes** and **amoeboid trophozoites** are characteristic, unlike the multiple rings seen in P. falciparum. *Plasmodium malariae* - Produces **band-form trophozoites** that span across the RBC diameter and **rosette-pattern schizonts**. - **72-hour fever cycle** and **no RBC enlargement**, but lacks the multiple ring forms typical of P. falciparum. *Plasmodium ovale* - Shows **oval-shaped RBCs** with **fimbriated edges** and **Schüffner's dots** similar to P. vivax. - **Single ring forms** per RBC and **compact trophozoites**, not the multiple rings characteristic of P. falciparum infections.
Explanation: **Explanation:** The production of monoclonal antibodies (mAbs) is based on the **Hybridoma Technology** developed by Kohler and Milstein. The **Mouse** is the primary animal used for this process because its immune system is well-characterized, and murine myeloma cells (cancerous B-cells) are readily available and highly compatible for fusion. In this process, a mouse is immunized with a specific antigen. Its B-lymphocytes (which produce antibodies but cannot grow indefinitely) are harvested from the spleen and fused with **immortal myeloma cells** using polyethylene glycol (PEG). The resulting "Hybridoma" cells possess the properties of both parents: they produce a single type of specific antibody (monoclonal) and can be cultured indefinitely. **Why other options are incorrect:** * **Rabbit:** Commonly used for producing **polyclonal antibodies** (antisera). While rabbit monoclonal technology exists, it is more complex and not the standard primary method taught in medical microbiology. * **Guinea pig:** Historically used for *in vivo* skin tests (e.g., the Schick test for Diphtheria or the Koch phenomenon for TB) and complement studies, but not for routine mAb production. * **Monkey:** Rarely used due to ethical concerns, high cost, and lack of standardized myeloma cell lines for fusion. **High-Yield NEET-PG Pearls:** * **Selection Medium:** **HAT Medium** (Hypoxanthine, Aminopterin, Thymidine) is used to select only the fused hybridoma cells. * **Nomenclature:** mAbs ending in **-omab** are 100% murine (mouse), **-ximab** are chimeric, **-zumab** are humanized, and **-umab** are fully human. * **Clinical Use:** Murine antibodies can cause "Human Anti-Mouse Antibodies" (HAMA) reactions, which is why newer mAbs are humanized.
Explanation: **Explanation:** This question tests the concept of **Bacterial Growth Kinetics**, specifically the calculation of population size during the exponential (log) phase. **1. Why Option A (512) is Correct:** The growth of a bacterial population can be calculated using the formula: **$N_n = N_0 \times 2^n$** * **$N_0$ (Initial number):** 1 bacterium. * **Generation Time ($G$):** 20 minutes (the time taken for one cell to divide into two). * **Total Time ($T$):** 3 hours = 180 minutes. * **Number of Generations ($n$):** Total time / Generation time = $180 / 20 = 9$ generations. Applying the formula: $1 \times 2^9 = 512$. Thus, after 3 hours, 512 bacteria will be present. **2. Why the Other Options are Incorrect:** * **Option B (440):** This is a distractor and does not follow the geometric progression ($2^n$) of bacterial growth. * **Option C (18):** This is a common error where the student multiplies the number of generations (9) by 2, rather than using it as an exponent. * **Option D (1024):** This represents $2^{10}$, which would be the population after 3 hours and 20 minutes (10 generations). **Clinical Pearls for NEET-PG:** * **Generation Time:** Also known as "doubling time." For *E. coli*, it is ~20 minutes, whereas for *Mycobacterium tuberculosis*, it is much slower (~12–20 hours), explaining the chronic nature of TB. * **Bacterial Growth Curve:** Consists of 4 phases: **Lag** (increase in size, not number), **Log/Exponential** (maximum metabolic activity; best for antibiotic action like Penicillin), **Stationary** (growth rate equals death rate; spores form here), and **Decline**. * **Calculation Tip:** Memorizing powers of 2 (e.g., $2^5=32, 2^{10}=1024$) is highly useful for quick calculations in the exam.
Explanation: **Explanation:** Louis Pasteur, often referred to as the "Father of Microbiology," made monumental contributions to vaccinology through the principle of **attenuation**—the process of weakening a pathogen so it can no longer cause disease but can still provoke an immune response. 1. **Chicken Cholera (1879):** This was Pasteur’s first discovery in the field of artificial vaccination. He accidentally found that aged cultures of *Pasteurella multocida* lost their virulence. When injected into chickens, these weakened bacteria protected them against subsequent infection with fresh, virulent strains. 2. **Anthrax (1881):** Pasteur successfully attenuated *Bacillus anthracis* by growing it at a higher temperature (42°C–43°C). He famously demonstrated the efficacy of this vaccine in a public trial at Pouilly-le-Fort, where vaccinated sheep survived a lethal challenge while the control group died. 3. **Rabies (1885):** This was Pasteur’s most celebrated achievement involving a human vaccine. Since viruses could not be cultured on agar then, he attenuated the rabies virus by serial passage through rabbits and drying the spinal cords. He successfully treated Joseph Meister, a young boy bitten by a rabid dog. **Why "All of the above" is correct:** Pasteur developed the foundational vaccines for all three diseases mentioned. While he did not discover the causative agents for all of them (e.g., Robert Koch discovered the Anthrax bacillus), Pasteur was the one who developed the **prophylactic vaccines** for them. **High-Yield Clinical Pearls for NEET-PG:** * **Germ Theory of Disease:** Proposed by Pasteur, disproving the theory of spontaneous generation. * **Pasteurization:** Developed to prevent spoilage in wine and milk. * **Other Contributions:** He coined the term "Vaccine" (in honor of Jenner's work with *vacca*/cowpox) and discovered the process of fermentation. * **Distinction:** Remember that while Pasteur developed the Anthrax vaccine, **Robert Koch** discovered the *Bacillus anthracis* bacterium and its spores.
Explanation: **Explanation:** The **Autoclave** is the gold standard for sterilization by **moist heat (steam) under pressure**. It operates on the principle that increasing the pressure in a closed vessel raises the boiling point of water, allowing steam to reach temperatures above 100°C. The standard cycle is **121°C at 15 psi for 15 minutes**, which is sufficient to kill all vegetative forms of bacteria, fungi, viruses, and, most importantly, highly resistant **bacterial spores**. **Analysis of Incorrect Options:** * **Tyndall’s Chamber / Tyndallization:** This is a method of intermittent steaming at 100°C for 20–30 minutes on three successive days. It is used for media containing heat-sensitive ingredients like sugar or gelatin. * **Koch’s Arnold Steamer:** This uses steam at atmospheric pressure (100°C) for 90 minutes. It is used for media that cannot withstand the high pressure of an autoclave. It does not reliably kill all spores in a single cycle. * **Hot Air Oven:** This is the primary method for **dry heat sterilization**. It operates at 160°C for 2 hours and is used for glassware, forceps, and oily substances that are impermeable to steam. **High-Yield Facts for NEET-PG:** * **Mechanism of Action:** Moist heat kills microorganisms by **denaturation and coagulation of structural proteins and enzymes**. * **Sterilization Control:** The biological indicator used to check the efficacy of an autoclave is **Geobacillus stearothermophilus** (formerly *Bacillus stearothermophilus*). * **Clinical Application:** Autoclaving is the preferred method for surgical instruments, culture media, and infectious waste. * **Flash Sterilization:** A rapid autoclaving method (134°C for 3 minutes) used for urgent surgical items.
Explanation: **Explanation:** The human gastrointestinal tract, particularly the large intestine, is a highly reduced environment with very low oxygen tension. This environment favors the growth of **obligate anaerobes**, which constitute the vast majority of the fecal biomass. **Why 1000:1 is correct:** In the colon, the concentration of bacteria is approximately $10^{11}$ to $10^{12}$ colony-forming units (CFU) per gram of stool. Of these, anaerobes (such as *Bacteroides fragilis*, *Clostridium* species, and *Bifidobacterium*) outnumber facultative anaerobes/aerobes (such as *E. coli* and *Enterococcus*) by a factor of **1000 to 1**. This ratio is a classic high-yield fact in medical microbiology, representing the extreme dominance of the anaerobic ecosystem in the distal gut. **Analysis of Incorrect Options:** * **A (10:1) & B (100:1):** These ratios significantly underestimate the anaerobic population. While these ratios might be seen in more proximal parts of the small intestine where oxygen levels are slightly higher, they do not reflect the dense anaerobic population of the stool. * **D (10000:1):** While the ratio can occasionally reach these levels in specific individuals or pathological states, the standard physiological average taught in medical textbooks (like Ananthanarayan or Jawetz) is 1000:1. **NEET-PG Clinical Pearls:** * **Most common anaerobe in stool:** *Bacteroides fragilis* is the most frequent isolate, though *Bifidobacterium* is also highly prevalent. * **Most common aerobe in stool:** *Escherichia coli*. * **Clinical Significance:** Disruption of this ratio (e.g., by broad-spectrum antibiotics like clindamycin) can lead to the overgrowth of *Clostridioides difficile*, resulting in pseudomembranous colitis. * **Sterility:** The GI tract is sterile at birth; colonization begins within hours, eventually establishing this 1000:1 ratio.
Explanation: **Explanation:** **NNN (Novy-MacNeal-Nicolle) medium** is the classic enrichment medium used for the cultivation of **Leishmania** species and **Trypanosoma cruzi**. It is a biphasic medium consisting of a solid phase (blood agar made with rabbit blood) and a liquid phase (overlay of saline or broth). 1. **Why Leishmania is correct:** When clinical samples (like bone marrow or splenic aspirates) are inoculated into NNN medium and incubated at 22–26°C, the amastigote form of the parasite transforms into the motile **promastigote** form, which can then be visualized under the microscope. This is a gold-standard diagnostic method for Visceral Leishmaniasis (Kala-azar). 2. **Why other options are incorrect:** * **Histoplasma:** This is a dimorphic fungus. It is typically cultured on **Sabouraud Dextrose Agar (SDA)** or Brain Heart Infusion (BHI) agar, not NNN medium. * **Trypanosoma:** While NNN medium can be used for *T. cruzi* (Chagas disease), it is not used for African Trypanosomiasis (*T. brucei*), which is usually diagnosed via blood film or lymph node aspirate. In the context of NEET-PG, NNN is most classically associated with Leishmania. * **Entamoeba:** *Entamoeba histolytica* is an intestinal protozoan cultured on specialized media like **Robinson’s medium** or **NIH polyxenic medium**. **High-Yield Clinical Pearls for NEET-PG:** * **Composition:** NNN medium specifically requires **defibrinated rabbit blood**. * **Temperature:** Incubation for Leishmania culture is done at **22–25°C** (room temperature), not 37°C. * **Other Media for Leishmania:** Schneider’s Drosophila medium (liquid medium). * **Diagnostic Gold Standard:** While culture is specific, the **RK39 immunochromatographic test** is the rapid diagnostic test of choice in field conditions.
Explanation: **Explanation:** The correct answer is **A. Vaccination of smallpox**. This is because the smallpox vaccine was developed by **Edward Jenner** in 1796, who is known as the "Father of Immunology." Jenner used the cowpox virus to provide cross-immunity against smallpox, a breakthrough that occurred nearly 26 years before Louis Pasteur was even born. **Analysis of other options:** * **Germ Theory (B):** Louis Pasteur is the pioneer of the Germ Theory of Disease. He disproved the theory of "spontaneous generation" through his famous swan-neck flask experiment, proving that microorganisms cause fermentation and disease. * **Pasteurization (C):** Named after him, this process involves heating liquids (like milk or wine) to a specific temperature to kill pathogenic bacteria, thereby preventing spoilage and disease. * **Vaccination of Rabies (D):** Pasteur developed the first vaccine for rabies (1885) and anthrax. He also coined the term "vaccine" in honor of Jenner's work with *vacca* (cow). **High-Yield Clinical Pearls for NEET-PG:** * **Louis Pasteur’s Contributions:** Discovered the principles of fermentation, developed liquid media for culture, and identified organisms like *Staphylococcus* and *Streptococcus*. * **Edward Jenner:** Associated with the first live vaccine (Smallpox). * **Robert Koch:** Known for Koch’s Postulates and discovering the causative agents of Anthrax, Cholera, and Tuberculosis. * **Joseph Lister:** Known as the "Father of Antiseptic Surgery" for using carbolic acid (phenol).
Explanation: **Explanation:** The B cell receptor (BCR) is a transmembrane protein complex located on the surface of B cells. It is composed of a membrane-bound immunoglobulin (mIg) molecule and a signal transduction moiety (Ig-α/Ig-β). **Why IgM is the correct answer:** Naïve B cells (B cells that have not yet encountered an antigen) predominantly express **monomeric IgM** and **IgD** on their surfaces. Among these, **IgM** is the primary functional receptor responsible for antigen recognition and the subsequent activation of the B cell. While IgM in the serum exists as a pentamer, it exists strictly as a monomer when acting as a BCR. **Analysis of Incorrect Options:** * **IgG:** This is the most abundant immunoglobulin in the serum and is responsible for secondary immune responses, opsonization, and placental transfer. It is not found on naïve B cells. * **IgA:** Primarily found in secretions (mucosal immunity) as a dimer. It does not function as a primary BCR on naïve cells. * **IgD:** Although IgD is co-expressed with IgM on naïve B cells, its specific physiological function is less defined, and IgM is considered the classic marker and functional receptor for B cell activation. **NEET-PG High-Yield Pearls:** * **Isotype Switching:** Once a B cell is activated, it can switch from producing IgM to IgG, IgA, or IgE; however, the specificity for the antigen remains the same. * **Pentameric vs. Monomeric:** Serum IgM is a **pentamer** (connected by a J-chain) and is the first antibody produced in a primary immune response. Surface IgM (BCR) is always a **monomer**. * **B Cell Markers:** Apart from the BCR, B cells are identified by surface markers **CD19, CD20, and CD21**.
History and Scope of Microbiology
Practice Questions
Classification of Microorganisms
Practice Questions
Bacterial Morphology and Structure
Practice Questions
Bacterial Physiology and Metabolism
Practice Questions
Bacterial Genetics
Practice Questions
Microbial Growth and Nutrition
Practice Questions
Sterilization and Disinfection
Practice Questions
Bacterial Identification Methods
Practice Questions
Normal Microbiota and Pathogenicity
Practice Questions
Antimicrobial Susceptibility Testing
Practice Questions
Get full access to all questions, explanations, and performance tracking.
Start For Free